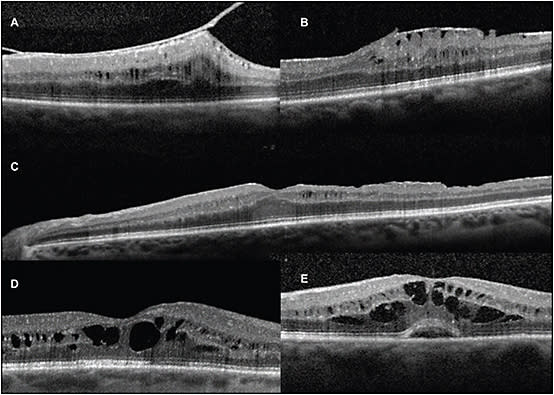
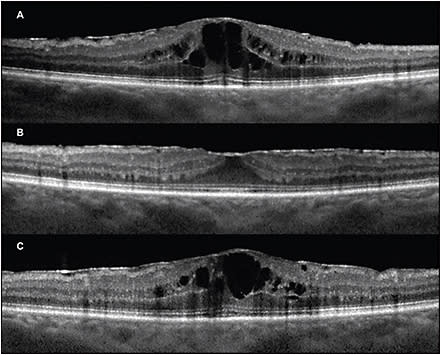

Managing Pseudophakic Cystoid Macular Edema
Advancements have been made with current imaging.
ERIC J. SIGLER, MD
Pseudophakic cystoid macular edema is a common form of uveitic macular edema occurring following cataract extraction. While uveitic macular edema has many underlying causes, CME has been widely recognized as a common form of visual decline or failure to achieve good vision in the immediate postoperative period in a large proportion of patients undergoing cataract surgery.
Gass and Irvine1-4 independently described the entity in the era of intracapsular cataract extraction. At that time, no optical coherence tomography evaluation was available, and phacoemulsification did not exist. Gass and others reported many in-depth observations of the disorder,1,3 including histologic specimens, which helped to define our knowledge of the unique structure of the macula and its response to anterior-segment inflammation.
Since then, CME has become less common,5 due to the development of phacoemulsification, decreased operating time, increased frequency of posterior-capsule integrity, and less anterior-segment surgical trauma. Nevertheless, CME continues to be a clinically meaningful complication in roughly 2% of modern cataract surgeries,5 and it is detectable via angiography in at least 30%.6
With the emergence of spectral-domain OCT, a remarkable amount of imaging detail is available in vivo that may facilitate early detection, guide treatment, and perhaps offer insight into the underlying mechanism of this common retinal disorder.
Eric J. Sigler, MD, practices in the Division of Retina and Vitreous at Ophthalmic Consultants of Long Island in Rockville Centre, NY. He reports no financial interests in products mentioned in this article. Dr. Sigler can be reached via e-mail at ejsigler@gmail.com.
PATHOPHYSIOLOGY
Cystoid macular edema is a macular retinal vascular edema in response to anterior-segment inflammation. While idiopathic and secondary forms of uveitis are well-known causes of macular edema, CME has some clinical and structural features that are distinct. These include the paucity of a robust cellular response in either the anterior segment or vitreous, relatively good vision, and a clear structural underpinning in many cases.
Factors known to influence the rate of development of CME include features involving the primary cataract extraction, underlying eye, or systemic factors. These include the presence of diabetic retinopathy or other retinal vascular disease,5 concomitant prostaglandin use,5,7 and disruption of the posterior lens capsule.6,8
Structural Relationships in CME
Integrity of the posterior lens capsule during the initial cataract extraction is perhaps the most important predisposing factor in CME development during the early postoperative period. Vitreous prolapse into the anterior segment is a commonly present variable, and residual vitreous traction has been implicated as a cause of CME.9,10
Idiopathic epimacular membrane (a.k.a., epiretinal membrane or macular pucker) or other hyaloidal processes, such as vitreomacular traction, can often be present in cases of CME, and they have been repeatedly implicated in recalcitrant or chronic CME.5
EXPANDING INTERPRETATION WITH CURRENT IMAGING
Recently, the author observed a consistent pattern of the structural evolution and resolution of acute CME. These initial investigations began with the observation that subclinical inner nuclear layer (INL) cystic changes could be present in a number of patients for a variety of reasons.
For example, cystic changes that result from epimacular membrane almost always involve the INL in mild cases, and the INL is typically the only retinal layer affected if a single layer is involved.
Because CME has long been known to demonstrate cystic spaces within the macula11-13 and to demonstrate a “petalloid” angiographic leakage pattern corresponding to Henle fibers and the outer plexiform layer (OPL),14,15 the notion that the structure on SD-OCT may provide information about the disease course was investigated.
Serial OCT images were examined during CME treatment and recurrence over a six-month period. We found that the structural pattern present was correlated with disease activity and that edema began in the INL.16 This region corresponds to the midretinal capillary plexus, and SD-OCT frequently reveals apparently dilated INL capillaries, which are not obvious in normal eyes.
The structural pattern of CME followed the pattern of INL to OPL and then to subretinal fluid as severity and visual decline worsened, with the earliest INL changes present as early as five days following cataract extraction.
Isolated OPL changes were not observed, and residual subretinal fluid upon intraretinal edema resolution often improved more gradually and did not indicate disease activity. We concluded that a specific pattern of SD-OCT structural changes was correlated with disease activity and severity in CME and that INL changes should be interpreted as disease activity.
Fluorescein angiographic patterns demonstrated multifocal intraretinal leakage without petalloid appearance with isolated INL edema, but petalloid edema was seen only when the OPL was involved, as previously reported. Similar SD-OCT patterns were recently reported for macular edema from multiple forms of uveitis.15,17
Interestingly, a proportion of patients with active CME demonstrated isolated INL cystic changes in their phakic, asymptomatic fellow eyes (Figure 1). This finding resolved upon treatment of the involved eye with periocular glucocorticoids, supporting the notion that a soluble inflammatory mediator or ocular reflex may be involved in CME.

Figure 1. Isolated inner nuclear layer cystic changes in the phakic fellow eye of a patient with acute pseudophakic cystoid macular edema. A) Arteriovenous phase fluorescein angiogram demonstrating mid-capillary perifoveal leakage six weeks after uncomplicated cataract extraction in the contralateral eye. B) Recirculation phase demonstrating late and mild disc leakage. C) SD-OCT of the the phakic unoperated eye displays isolated inner nuclear layer cysts. D) The operative eye demonstrates typical cystoid macular edema.
CYSTIC CHANGES IN THE INNER NUCLEAR LAYER
The INL has been the subject of recent debate,18 and it is perhaps the most common retinal layer involved in structural changes on SD-OCT. We have hypothesized that structural causes of INL cystic changes may be the result of internal limiting membrane traction and that Müller cell death may be the underlying etiology.
This theory is consistent with our recent description of delayed onset INL cystic changes following ILM peeling,19 and we have anecdotally seen this phenomenon more commonly when picks, rakes, or scrapers are employed.
A challenge arises in differentiating edema from nonvasogenic forms of cystic change, such as those that occur secondary to vitreomacular pathology. In the author’s experience, purely structural cystic spaces demonstrate an inner retinal surface contour abnormality, such as epimacular membrane, VMT, clear previous epiretinal surgical trauma, or altered foveal anatomy as demonstrated in Figure 2. One exception to this notion is the acquired emmetropic macular schisis that remains stable with OPL morphology on SD-OCT and has little effect on visual acuity.
Figure 2. Differentiating SD-OCT features of structural retinal cystic changes and macular edema. A) Inner nuclear layer (INL) cystic changes within a region of epimacular membrane and vitreomacular traction and inner retinal contour abnormality. B) INL cystic changes underlying area of epimacular membrane. C) Delayed-onset INL cystic changes appearing three months following membrane scraper trauma. D) Typical two- and (E) three-layer cystoid macular edema with combined INL and outer plexiform morphology in addition to subretinal fluid.
Isolated INL cystic changes are common in all forms of uveitic edema, and these changes are the primary OCT indicator of vasogenic edema in the absence of epiretinal pathology. This finding is important for diagnosis and treatment, as well as in considering newly reported SD-OCT findings such as “inner retinal microcysts,”20 which have been reported secondary to retrograde synaptic degeneration in multiple sclerosis, glaucoma, and other optic neuropathies. In the author’s opinion, these findings may simply represent subclinical uveitic macular edema.18
TREATMENT
CME treatment currently revolves around topical, periocular, and intravitreal anti-inflammatory agents, with occasional surgery for tractional components of CME. Nonsteroidal anti-inflammatory agents, such as indomethacin,21 ketorolac, nepafenac, and bromfenac, have been reported in multiple series5,22,23 to be effective in preventing CME development and in the treatment of visually significant CME.22-24
These agents are typically used in conjunction with topical glucocorticoids and are the standard primary medical therapy for most ophthalmologists. Cessation of topical prostaglandin analogs is recommended due to their implication in CME pathogenesis,5,25 and they are rarely important for acute intraocular pressure management.
The retinal physician will frequently, however, be presented with patients with active CME despite maximal topical therapy, indicating the limited effectiveness of topical therapy in some cases. In addition, topical therapy requires patient compliance.
Topical therapy, if effective, typically leads to gradual CME resolution over a period of one to three months. Therefore, periocular or intravitreal glucocorticoids are frequently used to cause more rapid resolution of CME.
Periocular glucocorticoid is commonly administered with 1 mL of 40 mg/mL triamcinolone acetonide in a sub-Tenon’s capsule location. This therapy has a variable duration of action, but anecdotally, and in the author’s experience, it lasts between four and eight weeks.
Because CME is usually a transient phenomenon that requires an initial anti-inflammatory dose to resolve more rapidly, this therapy is often all that is required for patients to experience complete resolution without further treatment. Although topical therapy may be continued following periocular administration, there is probably no benefit to continued topical corticosteroids.
In this context, the author has found no benefit to continued NSAIDs. Most patients (more than 90%) rapidly respond to sub-Tenon’s triamcinolone with either complete edema resolution within one to two weeks or resolution of intraretinal edema with residual subretinal fluid that gradually improves without further treatment.16
Intravitreal triamcinolone acetonide (eg, 4 mg/0.1 mL) may also be used effectively26; however, it has the additional risk of endophthalmitis and an increased rate of acute and chronic steroid-induced intraocular pressure elevation.
Ozurdex (0.7 mg sustained-release dexamethasone, Allergan, Irvine, CA) has been FDA approved for the treatment of posterior uveitis, and it is a recently available agent that has an intravitreal duration of action of roughly three months. There are many potential benefits of this medication as intravitreal therapy for CME, including rapid edema resolution, relatively long duration of action, and predictable dosing. Virtually all patients will experience some or complete resolution of CME following intravitreal therapy.
Anti-VEGF Agents and Surgery
Anti-VEGF therapy with bevacizumab (Avastin, Genentech, South San Francisco, CA) has been investigated27-29 with mixed results. However, in the author’s opinion, it makes little sense to use an antineovascular agent for an inflammatory condition.
Anti-VEGF therapy may improve some elements of vascular hyperpermeability, however, and it is a reasonable option to consider in chronic CME patients who cannot tolerate corticosteroid therapy.29
Despite the effectiveness of medical therapy, both refractory and recurrent cases occasionally occur. These patients can typically be divided into one of two categories: those with a clinically detectable structural abnormality, such as vitreous traction in the anterior segment, iris trauma, or epimacular pathology; and those with no obvious structural abnormality.
Common iris abnormalities include iris sutures, intraocular lens tilt inducing iris traction, or vitreous-induced corectopia. When these factors are present, structural repair with pars plana vitrectomy and relief of vitreous or iris traction is indicated.
Pars plana vitrectomy with removal of vitreous adhesions and ILM peeling has been demonstrated as an effective treatment in this scenario.30-32 Although refractory cases with tractional pathology require surgical repair, some cases with vitreous anomalies of the anterior segment and ERM may be initially treated with medical therapy.
In the author’s experience, epimacular membrane does not prevent CME resolution with medical therapy, but it does contribute to an increased rate of recurrence, as demonstrated in Figure 3.
Figure 3. Cystoid macular edema with epimacular membrane response to intravitreal dexamethasone implant. A) SD-OCT demonstrating diffuse cystoid macular edema (CME) with epimacular membrane one month following uncomplicated cataract extraction with visual acuity of 20/200. B) Two weeks following intravitreal dexamethasone 0.7 mg implant, the CME resolved, and the patient’s VA returned to 20/30. C) Early recurrence nine weeks later.
A challenging scenario arises when recurrent or persistent CME appears in the absence of any structural abnormality, for example, with an intact posterior capsule and no obvious epimacular pathology.
One theory is that these patients may have some structural abnormality of the retroiridal space, such as capsular traction to the pars plicata or haptics in contact with the intermediate uvea in some location. Alternatively, patients may have an underlying genetically determined immune variation that predisposes to inflammation in response to the presence of an intraocular lens or previous lens extraction.
In this context, PPV with the induction of hyaloid membrane separation and ILM peeling may still be considered, and it has been reported to improve vision and stabilize the course of chronic CME.30-32 The smallest possible gauge vitrectomy instrumentation, with forceps (not a scraper, pick, or rake) membrane peeling, should be employed with an ILM stain, such as brilliant blue G, to minimize uveal and retinal trauma.
The author advises a treatment algorithm for acute CME involving initial topical therapy followed by periocular corticosteroids for nonresponders and then intravitreal dexamethasone implantation for the few patients who demonstrate persistent edema.
Monthly SD-OCT examination can detect treatment response and early recurrence (isolated INL cystic changes). Any structural abnormalities should be repaired, such as anterior-segment vitreous adhesions or vitreomacular pathology, with vitrectomy and ILM peeling.
Despite even combined topical, intravitreal, and surgical intervention, some patients (even postvitrectomy) will develop chronic and or recurrent CME that may be present years after cataract extraction.
In the absence of structural abnormalities that may be mechanically repaired with surgery, chronic topical therapy with intermittent periocular or intravitreal corticosteroid may stabilize vision at an acceptable level.
FUTURE DIRECTIONS
As cataract extraction techniques and lens implant material continue to improve, CME may become slightly less common. However, this postsurgical problem will likely remain a clinically significant cause of failure to achieve good vision following eye surgery, with an overall good prognosis.
Sustained-release corticosteroids, such as Iluvien (Alimera, Alpharetta, GA) may be an effective long-term option for patients with chronic CME; however, the risk of steroid-induced glaucoma must be balanced with the risk of long-term visual disability from CME, which is typically a self-limited disorder.
Multiple intravitreal and sustained release anti-inflammatory agents, such as TriMoxi (Imprimis, San Diego, CA), are being investigated to replace the need for topical agents post-cataract extraction. Experience will demonstrate how such agents may eventually change the incidence of CME. RP
REFERENCES
1. Gass JD, Norton EW. Fluorescein studies of patients with macular edema and papilledema following cataract extraction. Trans Am Ophthalmol Soc. 1966;64:232-249.
2. Irvine SR. A newly defined vitreous syndrome following cataract surgery. Am J Ophthamol. 1953;36:599-619.
3. Gass JD, Norton EW. Cystoid macular edema and papilledema following cataract extraction. A fluorescein fundoscopic and angiographic study. Arch Ophthalmol. 1966;76:646-661.
4. Gass JD, Anderson DR, Davis EB. A clinical, fluorescein angiographic, and electron microscopic correlation of cystoid macular edema. Am J Ophthamol. 1985;100:82-86.
5. Henderson BA, Kim JY, Ament CS, Ferrufino-Ponce ZK, Grabowska A, Cremers SL. Clinical pseudophakic cystoid macular edema. Risk factors for development and duration after treatment. J Cataract Refract Surg. 2007;33:1550-1558.
6. Wright PL, Wilkinson CP, Balyeat HD, Popham J, Reinke M. Angiographic cystoid macular edema after posterior chamber lens implantation. Arch Ophthalmol. 1988;106:740-744.
7. Arcieri ES, Santana A, Rocha FN, Guapo GL, Costa VP. Blood-aqueous barrier changes after the use of prostaglandin analogues in patients with pseudophakia and aphakia: a 6-month randomized trial. Arch Ophthalmol. 2005;123:186-192.
8. Albert DW, Wade EC, Parrish RK 2nd, et al. A prospective study of angiographic cystoid macular edema one year after Nd: YAG posterior capsulotomy. Ann Ophthalmol. 1990;22:139-143.
9. Sebag J, Balazs EA. Pathogenesis of cystoid macular edema: an anatomic consideration of vitreoretinal adhesions. Surv Ophthalmol. 1984;28(Suppl):S493-S498.
10. Schepens CL, Avila MP, Jalkh AE, Trempe CL. Role of the vitreous in cystoid macular edema. Surv Ophthalmol. 1984;28(Suppl):S499-S504.
11. Yanoff M, Fine BS, Brucker AJ, Eagle RC Jr. Pathology of human cystoid macular edema. Surv Ophthalmol. 1984;28(Suppl):505-511.
12. Wolter JR. The histopathology of cystoid macular edema. Graefes Arch Clin Exp Ophthalmol. 1981;216:85-101.
13. Wolter JR. Cystoid macular edema in vitreo-retinal traction. Ophthalmic Surg. 1981;12:900-904.
14. Markomichelakis NN, Halkiadakis I, Pantelia E, et al. Patterns of macular edema in patients with uveitis: qualitative and quantitative assessment using optical coherence tomography. Ophthalmology. 2004;111:946-953.
15. Munk MR, Bolz M, Huf W, et al. Morphologic and functional evaluations during development, resolution, and relapse of uveitis-associated cystoid macular edema. Retina. 2013;33:1673-1683.
16. Sigler EJ, Randolph JC, Kiernan DF. Longitudinal analysis of the structural pattern of pseudophakic cystoid macular edema using multimodal imaging. Graefes Arch Clin Exp Ophthalmol. 2015 Apr 12. [Epub ahead of print]
17. Tran TH, de Smet MD, Bodaghi B, Fardeau C, Cassoux N, Lehoang P. Uveitic macular oedema: correlation between optical coherence tomography patterns with visual acuity and fluorescein angiography. Br J Ophthalmol. 2008;92:922-927.
18. Sigler EJ. Microcysts in the inner nuclear layer, a nonspecific SD-OCT sign of cystoid macular edema. Invest Ophthalmol Vis Sci. 2014;55:3282-3284.
19. Sigler EJ, Randolph JC, Charles S. Delayed onset inner nuclear layer cystic changes following internal limiting membrane removal for epimacular membrane. Graefes Arch Clin Exp Ophthalmol. 2013;251:1679-1685.
20. Abegg M, Dysli M, Wolf S, Kowal J, Dufour P, Zinkernagel M. Microcystic macular edema: retrograde maculopathy caused by optic neuropathy. Ophthalmology. 2014;121:142-149.
21. Yannuzzi LA, Landau AN, Turtz AI. Incidence of aphakic cystoid macular edema with the use of topical indomethacin. Ophthalmology. 1981;88:947-954.
22. Wittpenn JR, Silverstein S, Heier J, et al; Acular LS for Cystoid Macular Edema (ACME) Study Group. A randomized, masked comparison of topical ketorolac 0.4% plus steroid vs steroid alone in low-risk cataract surgery patients. Am J Ophthamol. 2008;146:554-560.
23. Warren KA, Bahrani H, Fox JE. NSAIDs in combination therapy for the treatment of chronic pseudophakic cystoid macular edema. Retina. 2010;30:260-266.
24. Yilmaz T, Cordero-Coma M, Gallagher MJ. Ketorolac therapy for the prevention of acute pseudophakic cystoid macular edema: a systematic review. Eye (Lond). 2012;26:252-258.
25. Altintas O, Yüksel N, Karabas VL, Demirci G. Cystoid macular edema associated with latanoprost after uncomplicated cataract surgery. Eur J Ophthalmol. 2005;15:158-161.
26. Sevim MS, Sanisoglu H, Turkyilmaz K. Intravitreal triamcinolone acetonide versus pars plana vitrectomy for pseudophakic cystoid macular edema. Curr Eye Res. 2012;37:1165-1170.
27. Spitzer MS, Ziemssen F, Yoeruek E, Petermeier K, Aisenbrey S, Szurman P. Efficacy of intravitreal bevacizumab in treating postoperative pseudophakic cystoid macular edema. J Cataract Refract Surg. 2008;34:70-75.
28. Spitzer MS, Szurman P, Bartz-Schmidt KU. Intravitreal bevacizumab in postoperative pseudophakic cystoid macular edema: does it really work? J Cataract Refract Surg. 2008;34:880; author reply 880-881.
29. Arevalo JF, Maia M, Garcia-Amaris RA, et al; Pan-American Collaborative Retina Study Group. Intravitreal bevacizumab for refractory pseudophakic cystoid macular edema: the Pan-American Collaborative Retina Study Group results. Ophthalmology. 2009;116:1481-1487.
30. Patel A, de Bustros S, Michels RG. Pars plana vitrectomy for aphakic cystoid macular edema. Retina. 1985;5:11-15.
31. Peyman GA, Canakis C, Livir-Rallatos C, Conway MD. The effect of internal limiting membrane peeling on chronic recalcitrant pseudophakic cystoid macular edema: a report of two cases. Am J Ophthamol. 2002;133:571-572.
32. Harbour JW, Smiddy WE, Rubsamen PE, Murray TG, Davis JL, Flynn HW Jr. Pars plana vitrectomy for chronic pseudophakic cystoid macular edema. Am J Ophthamol. 1995;120:302-307.








